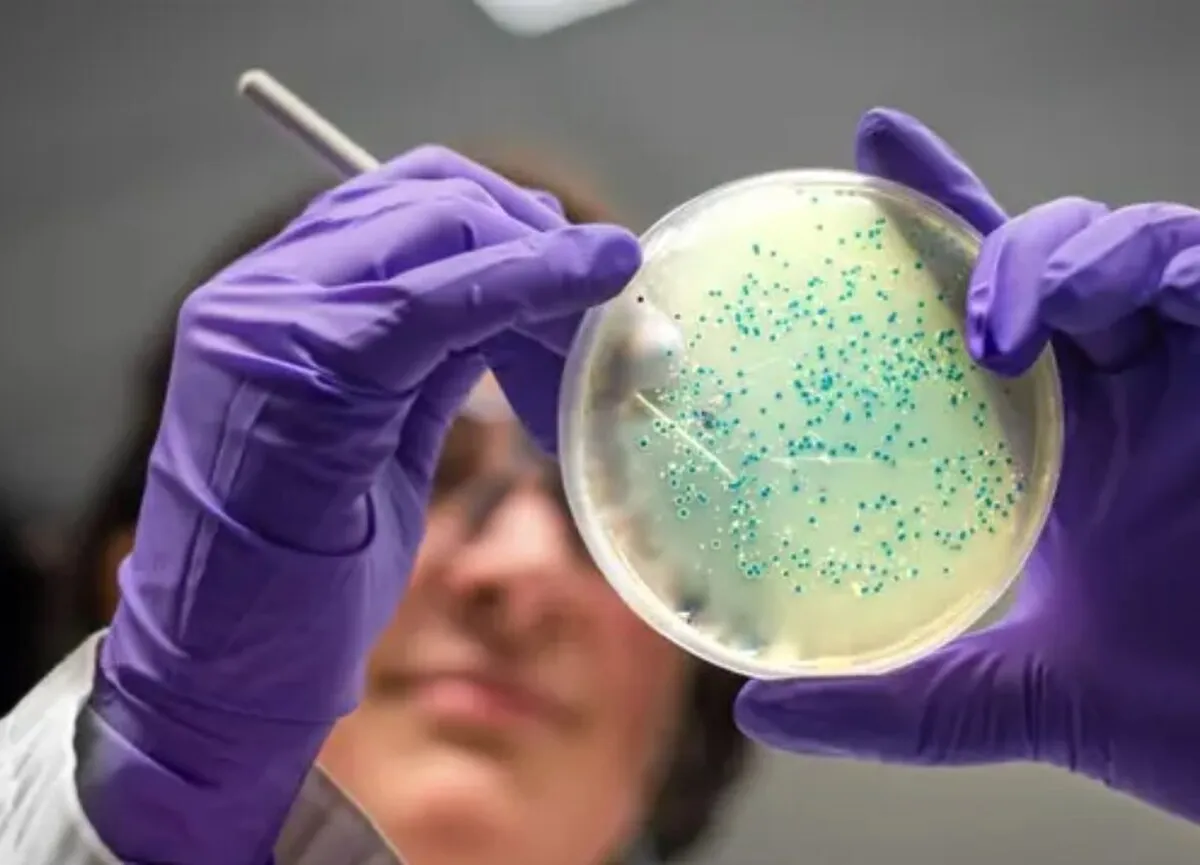

ابداع تجزیهگر سریع پلاستیکها با الهام از صدف دریایی
به گزارش خبرگزاری آنا و به نقل از IE، طی سالهای اخیر دانشمندان به طور فعال به دنبال راه حلهایی برای مقابله با مشکل فزاینده زبالههای پلاستیکی بوده اند. شوربختانه، تجزیه پلاستیک ممکن است صدها سال طول بکشد. همانطور که پلاستیک به قطعات کوچکتر تجزیه میشود، حذف آن دشوارتر میشده و خطرات بیشتری برای حیات وحش و زیست بومها ایجاد میکند.
پژوهشگران دانشگاه رایس در آمریکا از خواص چسبندگی طبیعی صدفهای دریایی برای ساخت میکروارگانیسمهای مهندسی زیستی استفاده کردند که میتوانند با قدرت به سطوح بچسبند.
«هان شیائو» «Han Xiao»، سرپرست این گروه تحقیقاتی و دانشیار شیمی، علوم زیستی و مهندسی زیستی، گفت: «بسیار هیجان انگیز است که تحقیقات ما نویدبخش پرداختن به مشکل رو به رشد آلودگی پلاستیک در سراسر جهان شده است.»
فقط در آمریکا، سالانه، ۴۰ میلیون تن زباله پلاستیکی تولید میشود. پلی اتیلن ترفتالات (PET) - نوعی پلاستیک - بخش اصلی این زباله (۶۴ ٪) را تشکیل میدهد که تجزیه آن ممکن است قرنها طول بکشد.
محققان باکتریها و پروتئینهای چسبندهای تولید کردند که میتوانند به تجزیه PET به طور موثرتری کمک کنند. جالب آنکه این دستاورد میتواند ابزار ارزشمندی در کاهش آلودگی پلاستیکی در سراسر جهان باشد.
در این توسعه، محققان از روشی به نام «گسترش کد ژنتیکی» برای اصلاح باکتریها استفاده کردند.
آنها یک اسید آمینه طبیعی به نام ۳، ۴- دی هیدروکسی فنیل آلانین (DOPA) را وارد کد ژنتیکی باکتری کردند. DOPA که در صدفها یافت میشود، عامل ایجاد توانایی آنها برای چسبیدن به سطوح است.
این روش به طور قابل توجهی توانایی باکتریها را برای چسبیدن به سطوح PET افزایش داد و باکتریها را در تجزیه پلاستیک PET موثرتر کرد.
مجریان این طرح میگویند: «رویکرد ما بر استفاده نوآورانه گسترش کد ژنتیکی در مهندسی مواد و سلولی تأکید دارد و به طور بالقوهای میتواند برنامههای مهندسی زیستی را تغییر داده و مشکلات دنیای واقعی را حل کند.»
باکتریهای مهندسی شده وقتی در دمای ۳۷ درجه سانتیگراد آزمایش شدند، افزایش ۴۰۰ برابری چسبندگی به بسترهای PET را نشان دادند.
علاوه بر این، این باکتریهای چسبنده با آنزیمی به نام «پلی اتیلن ترفتالات هیدرولاز» ترکیب شدند تا پلاستیک را تجزیه کنند.
این فناوری منجر به دستاوردی شد که محققان آن را تخریب یک شبه حجم زیادی پلاستیک مینامند.
دانش پژوهان علاوه بر مقابله با آلودگی پلاستیکی، راههایی را برای جلوگیری از رسوب زیستی که یک مشکل بزرگ در صنایعی مانند کشتیرانی، ساخت و سازهای دریایی و تصفیه آب است، نیز پیشنهاد میکنند.
رسوب زیستی زمانی اتفاق میافتد که میکروارگانیسم ها، گیاهان، جلبکها و حیوانات کوچک به سطوح زیر آب بچسبند. چنین پدیدهای میتواند به بدنه کشتی، سازههای زیر آب و لولهها آسیب وارد کرده و در نتیجه هزینههای نگهداری را افزایش دهد.
به همین منظور محققان دانشگاه رایس پروتئینهای اصلاح شدهای را با استفاده از روش DOPA ایجاد کردند. این پروتئینها یک لایه محافظ بر روی سطوح مختلف ایجاد میکنند که مانع از اتصال موجودات میشود.
بر اساس اعلام محققان، این پژوهش میتواند در طیف وسیعی از زمینهها از جمله مراقبتهای بهداشتی کاربرد داشته باشد. پروتئینهای اصلاح شده با DOPA میتوانند برای مهار چسبندگی باکتریها در دستگاههای پزشکی مورد استفاده قرار گیرند و ایمنی و کارایی آنها را افزایش دهند.
«منگسی ژانگ» «Mengxi Zhang» یکی دیگر از مجریان این مطالعه گفت: «این پژوهش راههای جدیدی را برای استفاده از این کنش و واکنشها به منظور توسعه ترکیبهای هوشمند ماده - پروتئین برای کاربردهای مختلف زیست پزشکی مانند دستگاههای پزشکی قابل کاشت، مهندسی بافت و تحویل دارو باز میکند.»
در یکی دیگر از پیشرفتهای اخیر، محققان دانشگاه نورث وسترن نوعی باکتری فاضلاب را کشف کردند که از PET تغذیه میکند. باکتری «کوماموناس تستوستری» از یک آنزیم برای تجزیه PET استفاده میکند.
نتایج این پژوهش در نشریه Small Methods منتشر شده است.
انتهای پیام/
- تور استانبول
- غذای سازمانی
- خرید کارت پستال
- لوازم یدکی تویوتا قطعات تویوتا
- مشاوره حقوقی
- تبلیغات در گوگل
- بهترین کارگزاری بورس
- ثبت نام آمارکتس
- سایت رسمی خرید فالوور اینستاگرام همراه با تحویل سریع
- یخچال فریزر اسنوا
- گاوصندوق خانگی
- تاریخچه پلاک بیمه دات کام
- ملودی 98
- خرید سرور اختصاصی ایران
- بلیط قطار مشهد
- رزرو بلیط هواپیما
- ال بانک
- آهنگ جدید
- بهترین جراح بینی ترمیمی در تهران
- اهنگ جدید
- خرید قهوه
- اخبار بورس
























